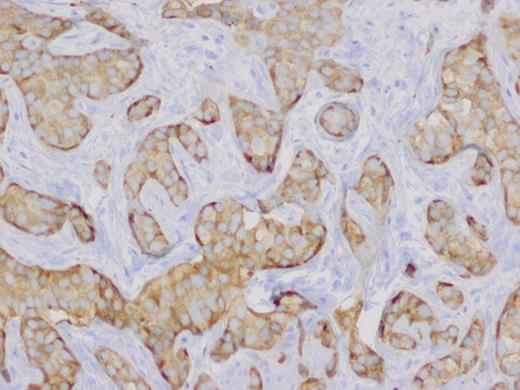
Synaptophysin positive neoplastic cells (magnification ×20).

-
PDF
- Split View
-
Views
-
Cite
Cite
Hoang U. Lim, Cyrus C. Chan, F. Barry Knotts, An incidental finding of carcinoid tumor of the cystic duct, Journal of Surgical Case Reports, Volume 2013, Issue 4, April 2013, rjt021, https://doi.org/10.1093/jscr/rjt021
Close - Share Icon Share
Abstract
Cystic duct carcinoids are extremely rare tumors. We present a 58-year-old female with carcinoid tumor found within the cystic duct margin following laparoscopic cholecystectomy. She subsequently underwent surgical resection with a Roux-en-Y hepaticojejunostomy. No standard guidelines currently exist regarding surgical excision of these rare tumors. Therefore, we conducted a thorough review of the literature to recommend complete oncologic surgical resection with re-establishment of biliary continuity as the mainstay of definitive treatment; adjuvant therapy currently remains investigational. Long-term prognosis is good with this approach.
INTRODUCTION
Carcinoid tumors are most commonly found in the appendix, but can be located anywhere along the gastrointestinal tract, within the ovary and even the lung [1]. Carcinoid tumor of the cystic duct is an extremely rare finding. A review of the literature reveals that there have been only seven previously reported cases [2–8].
CASE REPORT
A 58-year-old Caucasian female presented with episodic right upper quadrant pain for the past 2 weeks. The pain was associated with multiple episodes of nausea, vomiting and diarrhea. She denied any jaundice, weight loss, hematochezia or melena. Physical examination revealed a soft abdomen without a palpable mass. She had tenderness in the right upper quadrant of the abdomen and Murphy's sign was present. The white blood cell count was 18.8K/µl, hematocrit 41.0%, bilirubin 0.20 mg/dl, lipase 101 U/l, alkaline phosphatase 70 U/l, alanine aminotransferase 28 U/l and aspartate aminotransferase 30 U/l. Computed tomography of the abdomen showed an enlarged fatty liver, mildly prominent gallbladder and inflammatory changes and edema at the root of the mesentery. Abdominal ultrasound revealed gallbladder sludge and wall thickness measuring 2 mm. The patient underwent laparoscopic cholecystectomy. Pathology report revealed mild chronic cholecystitis with foci of cholesterolosis and a small 2 mm carcinoid tumor at the cystic duct margin extending into the gallbladder mucosa. Histologically, the tumor demonstrated uniform eosinophilic neoplastic cells with oval nucleus (Fig. 1) and was positive for chromogranin and synaptophysin neuroendocrine markers (Figs 2 and 3).

Carcinoid tumor at the cystic duct margin (H&E, magnification ×40).

The patient was returned to the operating room 15 days after her first operation for a Roux-en-Y heptaticojejunostomy and excisional biopsy of a large lymph node at the mesenteric root. Her preoperative urine 5-hydroxyindoleacetic acid (5-HIAA), chromogranin A and serotonin levels were all normal. Final pathology report showed no viable tumor identified on the common hepatic and common bile duct margins, focal residual necrotic carcinoid tumor involving the cystic duct margin and one periductal lymph node negative for carcinoid tumor. The mesenteric root lymph node was positive for follicular lymphoma. Post-operative course was unremarkable. Medical oncology was consulted and recommended no chemotherapy at this time. The patient was seen in clinic 10 months post-operatively and remains disease free with normal liver function and humoral secretion tests.
DISCUSSION
Carcinoid tumors arise from enterochromaffin cells (Kulchitsky cells) and usually present in the fifth decade of life. They are most commonly found in the appendix (45%), jejunoileum (28%) and rectum (16%) [1]. The majority of carcinoid tumors are asymptomatic and found incidentally during surgery. They frequently coexist with a second primary adenocarcinoma of the colon. The growth pattern for these tumors is slow with metastatic development after 7–14 years. Metastatic potential is dependent upon location, size, depth of invasion and growth pattern. Malignant carcinoid syndrome occurs in <10% of patients and signifies metastatic disease due to hepatic replacement.
The syndrome is characterized by flushing (80%), diarrhea (76%), asthma (25%) and right heart valvular disease (41–70%) [1]. The humoral factors that contribute to the syndrome include serotonin, 5-hydroxytryptophan, histamine, dopamine, kallikrein, substance P, prostaglandin and neuropeptide K. The diagnosis for carcinoid syndrome is highly specific when there are elevated urinary levels of 5-hydroxyindoleacetic acid over 24 h. The treatment for carcinoid tumors is dependent on size and presence of lymph node metastasis. Segmental intestinal resection is adequate for lesions <1 cm without lymph node involvement. For multifocal tumors or lesions >1 cm with lymph node involvement, standard oncologic resection is required [1].
Carcinoid tumors of the extra-hepatic biliary tract are uncommon and account for 0.2–2% of all gastrointestinal tract carcinoids. The etiology is unknown but is thought to be related to chronic inflammation of the biliary tract, which leads to metaplasia of the biliary mucosa. This results in an increased number of Kulchitsky cells and may lead to development of carcinoid tumors [4]. There have been only 70 cases of biliary tract carcinoid tumors reported since it was first discovered in 1959. Of these, the most common anatomic locations are the common bile duct (58%), perihilar duct (28%), cystic duct (11%) and common hepatic duct (3%) [9].
There are currently seven reported cases of cystic duct carcinoid tumor (Table 1) [2–8]. The most common main complaints were right upper quadrant pain and jaundice; malignant carcinoid syndrome has not been reported in this group. These tumors occur more often in women, with a female-to-male ratio of 3:1. There does not appear to be a direct correlation between tumor size and metastasis in carcinoid tumor of the cystic duct [7]. The tumors are discovered incidentally after surgical intervention and pathologic analysis. Complete surgical resection in patients with resectable biliary tumor remains the standard of care [1]. Long-term prognosis is good with a 10-year survival rate of 80% for carcinoid tumors of the extra-hepatic biliary tract [10].
| Case [2–8] . | Author . | Year . | Age . | Sex . | CC . | Size . | Mets . | Follow up . |
|---|---|---|---|---|---|---|---|---|
| 1 | Nicolescu et al. | 1986 | 50 | F | RUQ pain | 0.5 cm | None | Not reported |
| 2 | Chittal and Ra | 1989 | 46 | F | RUQ pain | 0.8 cm | None | DF, 36 months |
| 3 | Rugge et al. | 1992 | 64 | M | Jaundice | 2 cm | None | DF, 12 months |
| 4 | Meyer et al. | 1997 | 56 | F | RUQ pain | Small | None | DF, 48 months |
| 5 | Shah et al. | 1998 | 52 | F | RUQ pain | 0.5 cm | None | Not reported |
| 6 | Hermina et al. | 1999 | 69 | M | RUQ pain | Small | LN | Not reported |
| 7 | Felekouras et al. | 2007 | 60 | F | Jaundice | 2 cm | None | DF, 11 months |
| 8 | Present case | 2012 | 58 | F | RUQ pain | 0.2 cm | None | DF, 10 months |
| Case [2–8] . | Author . | Year . | Age . | Sex . | CC . | Size . | Mets . | Follow up . |
|---|---|---|---|---|---|---|---|---|
| 1 | Nicolescu et al. | 1986 | 50 | F | RUQ pain | 0.5 cm | None | Not reported |
| 2 | Chittal and Ra | 1989 | 46 | F | RUQ pain | 0.8 cm | None | DF, 36 months |
| 3 | Rugge et al. | 1992 | 64 | M | Jaundice | 2 cm | None | DF, 12 months |
| 4 | Meyer et al. | 1997 | 56 | F | RUQ pain | Small | None | DF, 48 months |
| 5 | Shah et al. | 1998 | 52 | F | RUQ pain | 0.5 cm | None | Not reported |
| 6 | Hermina et al. | 1999 | 69 | M | RUQ pain | Small | LN | Not reported |
| 7 | Felekouras et al. | 2007 | 60 | F | Jaundice | 2 cm | None | DF, 11 months |
| 8 | Present case | 2012 | 58 | F | RUQ pain | 0.2 cm | None | DF, 10 months |
CC, chief complaint; RUQ, right upper quadrant; DF, disease free; LN, lymph node.
| Case [2–8] . | Author . | Year . | Age . | Sex . | CC . | Size . | Mets . | Follow up . |
|---|---|---|---|---|---|---|---|---|
| 1 | Nicolescu et al. | 1986 | 50 | F | RUQ pain | 0.5 cm | None | Not reported |
| 2 | Chittal and Ra | 1989 | 46 | F | RUQ pain | 0.8 cm | None | DF, 36 months |
| 3 | Rugge et al. | 1992 | 64 | M | Jaundice | 2 cm | None | DF, 12 months |
| 4 | Meyer et al. | 1997 | 56 | F | RUQ pain | Small | None | DF, 48 months |
| 5 | Shah et al. | 1998 | 52 | F | RUQ pain | 0.5 cm | None | Not reported |
| 6 | Hermina et al. | 1999 | 69 | M | RUQ pain | Small | LN | Not reported |
| 7 | Felekouras et al. | 2007 | 60 | F | Jaundice | 2 cm | None | DF, 11 months |
| 8 | Present case | 2012 | 58 | F | RUQ pain | 0.2 cm | None | DF, 10 months |
| Case [2–8] . | Author . | Year . | Age . | Sex . | CC . | Size . | Mets . | Follow up . |
|---|---|---|---|---|---|---|---|---|
| 1 | Nicolescu et al. | 1986 | 50 | F | RUQ pain | 0.5 cm | None | Not reported |
| 2 | Chittal and Ra | 1989 | 46 | F | RUQ pain | 0.8 cm | None | DF, 36 months |
| 3 | Rugge et al. | 1992 | 64 | M | Jaundice | 2 cm | None | DF, 12 months |
| 4 | Meyer et al. | 1997 | 56 | F | RUQ pain | Small | None | DF, 48 months |
| 5 | Shah et al. | 1998 | 52 | F | RUQ pain | 0.5 cm | None | Not reported |
| 6 | Hermina et al. | 1999 | 69 | M | RUQ pain | Small | LN | Not reported |
| 7 | Felekouras et al. | 2007 | 60 | F | Jaundice | 2 cm | None | DF, 11 months |
| 8 | Present case | 2012 | 58 | F | RUQ pain | 0.2 cm | None | DF, 10 months |
CC, chief complaint; RUQ, right upper quadrant; DF, disease free; LN, lymph node.
Conflict of interest statement
We certify that we do not have any affiliation with or financial involvement in any organization or entity with a direct financial interest in the subject matter or materials discussed in the manuscript (e.g. employment, consultancies, stock ownership, honoraria and expert testimony). We do not have any commercial or proprietary interest in any drug, device, or equipment mentioned in the article above. No financial support was used for this work.